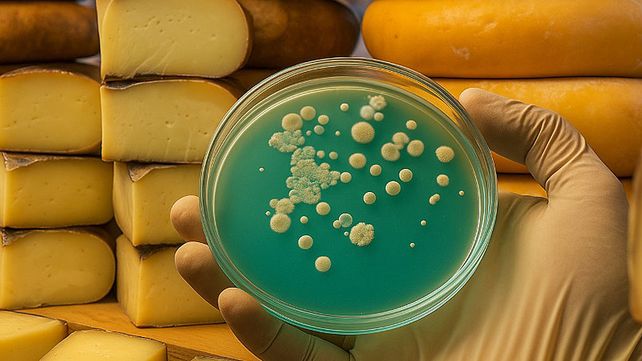

Desde la Facultad de Bromatología de la Universidad Nacional de Entre Ríos (UNER advirtieron sobre un brote de listeriosis en distintas provincias argentinas y difundieron datos importantes para prevenir esta c
Listeriosis: dan pautas de prevención de la transmisión
Tras un brote de listeriosis desde la Facultad de Bromatología brindan datos para prevenir esta enfermedad transmitida a través de alimentos
Tras un brote de listeriosis desde la Facultad de Bromatología brindan datos para prevenir esta enfermedad transmitida a través de alimentos
Tras un brote de listeriosis desde la Facultad de Bromatología brindan datos para prevenir esta enfermedad transmitida a través de alimentos
Mercedes Piaggio, docente e investigadora de esa Facultad, remarca la importancia de reforzar la manipulación segura de alimentos, especialmente en los grupos de riesgo: personas embarazadas, adultos mayores o inmunocomprometidas.
Síntomas
- La enfermedad puede ser grave en embarazadas, bebés, adultos mayores y personas con el sistema inmunológico debilitado.
- Los síntomas incluyen dolores estomacales, y en casos más graves, septicemia.
¿Qué es la listeriosis?
Es una enfermedad causada por la bacteria “Listeria monocytogenes”, que puede encontrarse en: quesos blandos, frescos o semiblandos, fiambres y embutidos listos para consumir (ALC), pescados ahumados refrigerados, patés y untables, lácteos no pasteurizados y otros productos listos para consumir sin cocción.
Esta bacteria puede desarrollarse incluso en refrigeración, por eso es clave seguir prácticas de higiene y conservación adecuadas
“La listeriosis puede prevenirse con información clara y prácticas responsables. Es fundamental que tanto consumidores como elaboradores estén informados sobre los riesgos y cómo evitarlos”, destacó Piaggio.
Prevención
Se recomienda
- Higiene personal y de los utensilios a utilizar para cocinar
- Evitar alimentos sin trazabilidad o de origen dudoso
- Mantener la cadena de frío desde la compra hasta el consumo
- Leer las etiquetas y asegurarse que los lácteos estén pasteurizados
- Cocinar completamente carnes y pescados
- Recalentar los alimentos listos para consumir (ALC) cuando sea posible
- Planear las comidas: si no va a congelar, preparar lo más cerca del momento de consumo
- En verduras congeladas, cocinar siguiendo las instrucciones del envase